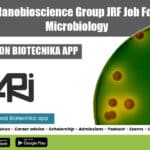
MACS-ARI Pune JRF
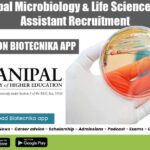
MAHE Manipal Vacancy 2022

Home Search
biology - search results
If you're not happy with the results, please do another search
Coca-Cola Biology & Food Science Recruitment, Apply Online
Coca-Cola Biology & Food Science Recruitment, Apply Online
Coca-Cola Biology & Food Science Recruitment, Apply Online. Coca-Cola India jobs. Supplier Auditor and Developer job openings...
Bayer Seed Analyst Job – MSc & PhD Microbiology, Mol Bio Apply Online
Bayer Seed Analyst Job - MSc & PhD Microbiology, Mol Bio Apply Online
Bayer Seed Analyst Job - MSc & PhD Microbiology, Mol Bio Apply...
CSIR-NEERI Microbiology Project Associate Recruitment, Applications Invited
NEERI Microbiology Project Job Opening, Applications Invited
NEERI Microbiology Project Job Opening, Applications Invited. MSc Microbiology project associate job at CSIR-NEERI. CSIR - National Environmental...
MACS ARI Nanobioscience Group JRF Job For Biotech & Microbiology
MACS-ARI Pune JRF Job For Biotech & Microbiology
MACS-ARI Pune JRF Job For Biotech & Microbiology. MSc Biotechnology and Microbiology JRF Job. JRF job openings...
MSc Biotech & Microbiology Job With 0 to 3 Years Exp at Springer Nature
Springer Nature Vacancy 2022 - Biotech & Microbiology Apply Online
Springer Nature Vacancy 2022 - Biotech & Microbiology Apply Online. MSc Biotechnology, Microbiology SJr. Editorial...
MAHE Manipal Microbiology & Life Sciences Research Assistant Recruitment
MAHE Manipal Vacancy 2022 - MSc Microbiology & Life Sciences
MAHE Manipal Vacancy 2022 - MSc Microbiology & Life Sciences. Manipal Academy of Higher Education...
MACS ARI Botany, Microbiology & Biotech JRF Recruitment
MACS ARI Botany, Microbiology & Biotech JRF Recruitment
MACS ARI Botany, Microbiology & Biotech JRF Recruitment. MSc Biotechnology, Botany and Microbiology JRF Job. JRF job...
MACS ARI JRF Job Opening For Biotech & Microbiology
MACS ARI JRF Job Opening For Biotech & Microbiology
MACS ARI JRF Job Opening For Biotech & Microbiology. MSc Microbiology/ Biotechnology JRF Job. JRF job...
Presidency University Student Internship 2022 For Biotech, Botany & Microbiology
Presidency University Student Internship 2022 For Biotech, Botany & Microbiology
Presidency University Student Internship 2022 For Biotech, Botany & Microbiology. Student internship vacancy. Interested and...
NABI Bioinformatics & Computational Biology JRF Posts Available
NABI Bioinformatics JRF Job - Computational Biology Can Apply
NABI Bioinformatics JRF Job - Computational Biology Can Apply. NABI Project Vacancies Available. NABI Research Fellow...
Biotecnika Times Newsletter 12.05.2022 Govt TIFAC Job, ITC Limited Hiring, Comp Biology Webinar
Biotecnika Times- Govt TIFAC Job, ITC Limited Hiring, Comp Biology
Govt of India DST, TIFAC Biotech & Biochem Young Professional Recruitment
Govt TIFAC Jobs 2022 –...
IISER Kolkata PhD Biology & Life Sciences COVID-19 Project Recruitment
IISER Kolkata PhD Biology & Life Sciences COVID-19 Project Recruitment
IISER Kolkata PhD Biology & Life Sciences COVID-19 Project Recruitment. PhD in Life science/ Biology...
VIT Vellore Bioinformatics, Computational Biology & Life Sciences JRF Post
VIT Vellore Bioinformatics, Computational Biology & Life Sciences JRF Post
VIT Vellore Bioinformatics, Computational Biology & Life Sciences JRF Post. MSc Life Sciences, Bioinformatics, Computational...
Teva Pharma Microbiology QC Technician Job – Apply Online
Teva Pharma Microbiology QC Technician Job - Apply Online
Teva Pharma Microbiology QC Technician Job - Apply Online. Microbiology Quality Control Technician II Job Opening....
TMC Kolkata Cell Biology Post Doctoral Fellow Recruitment
TMC Kolkata Cell Biology Post Doctoral Fellow Recruitment
TMC Kolkata Cell Biology Post Doctoral Fellow Recruitment. PhD Biological Sciences, Life Sciences, Biotechnology, Cell & Molecular...